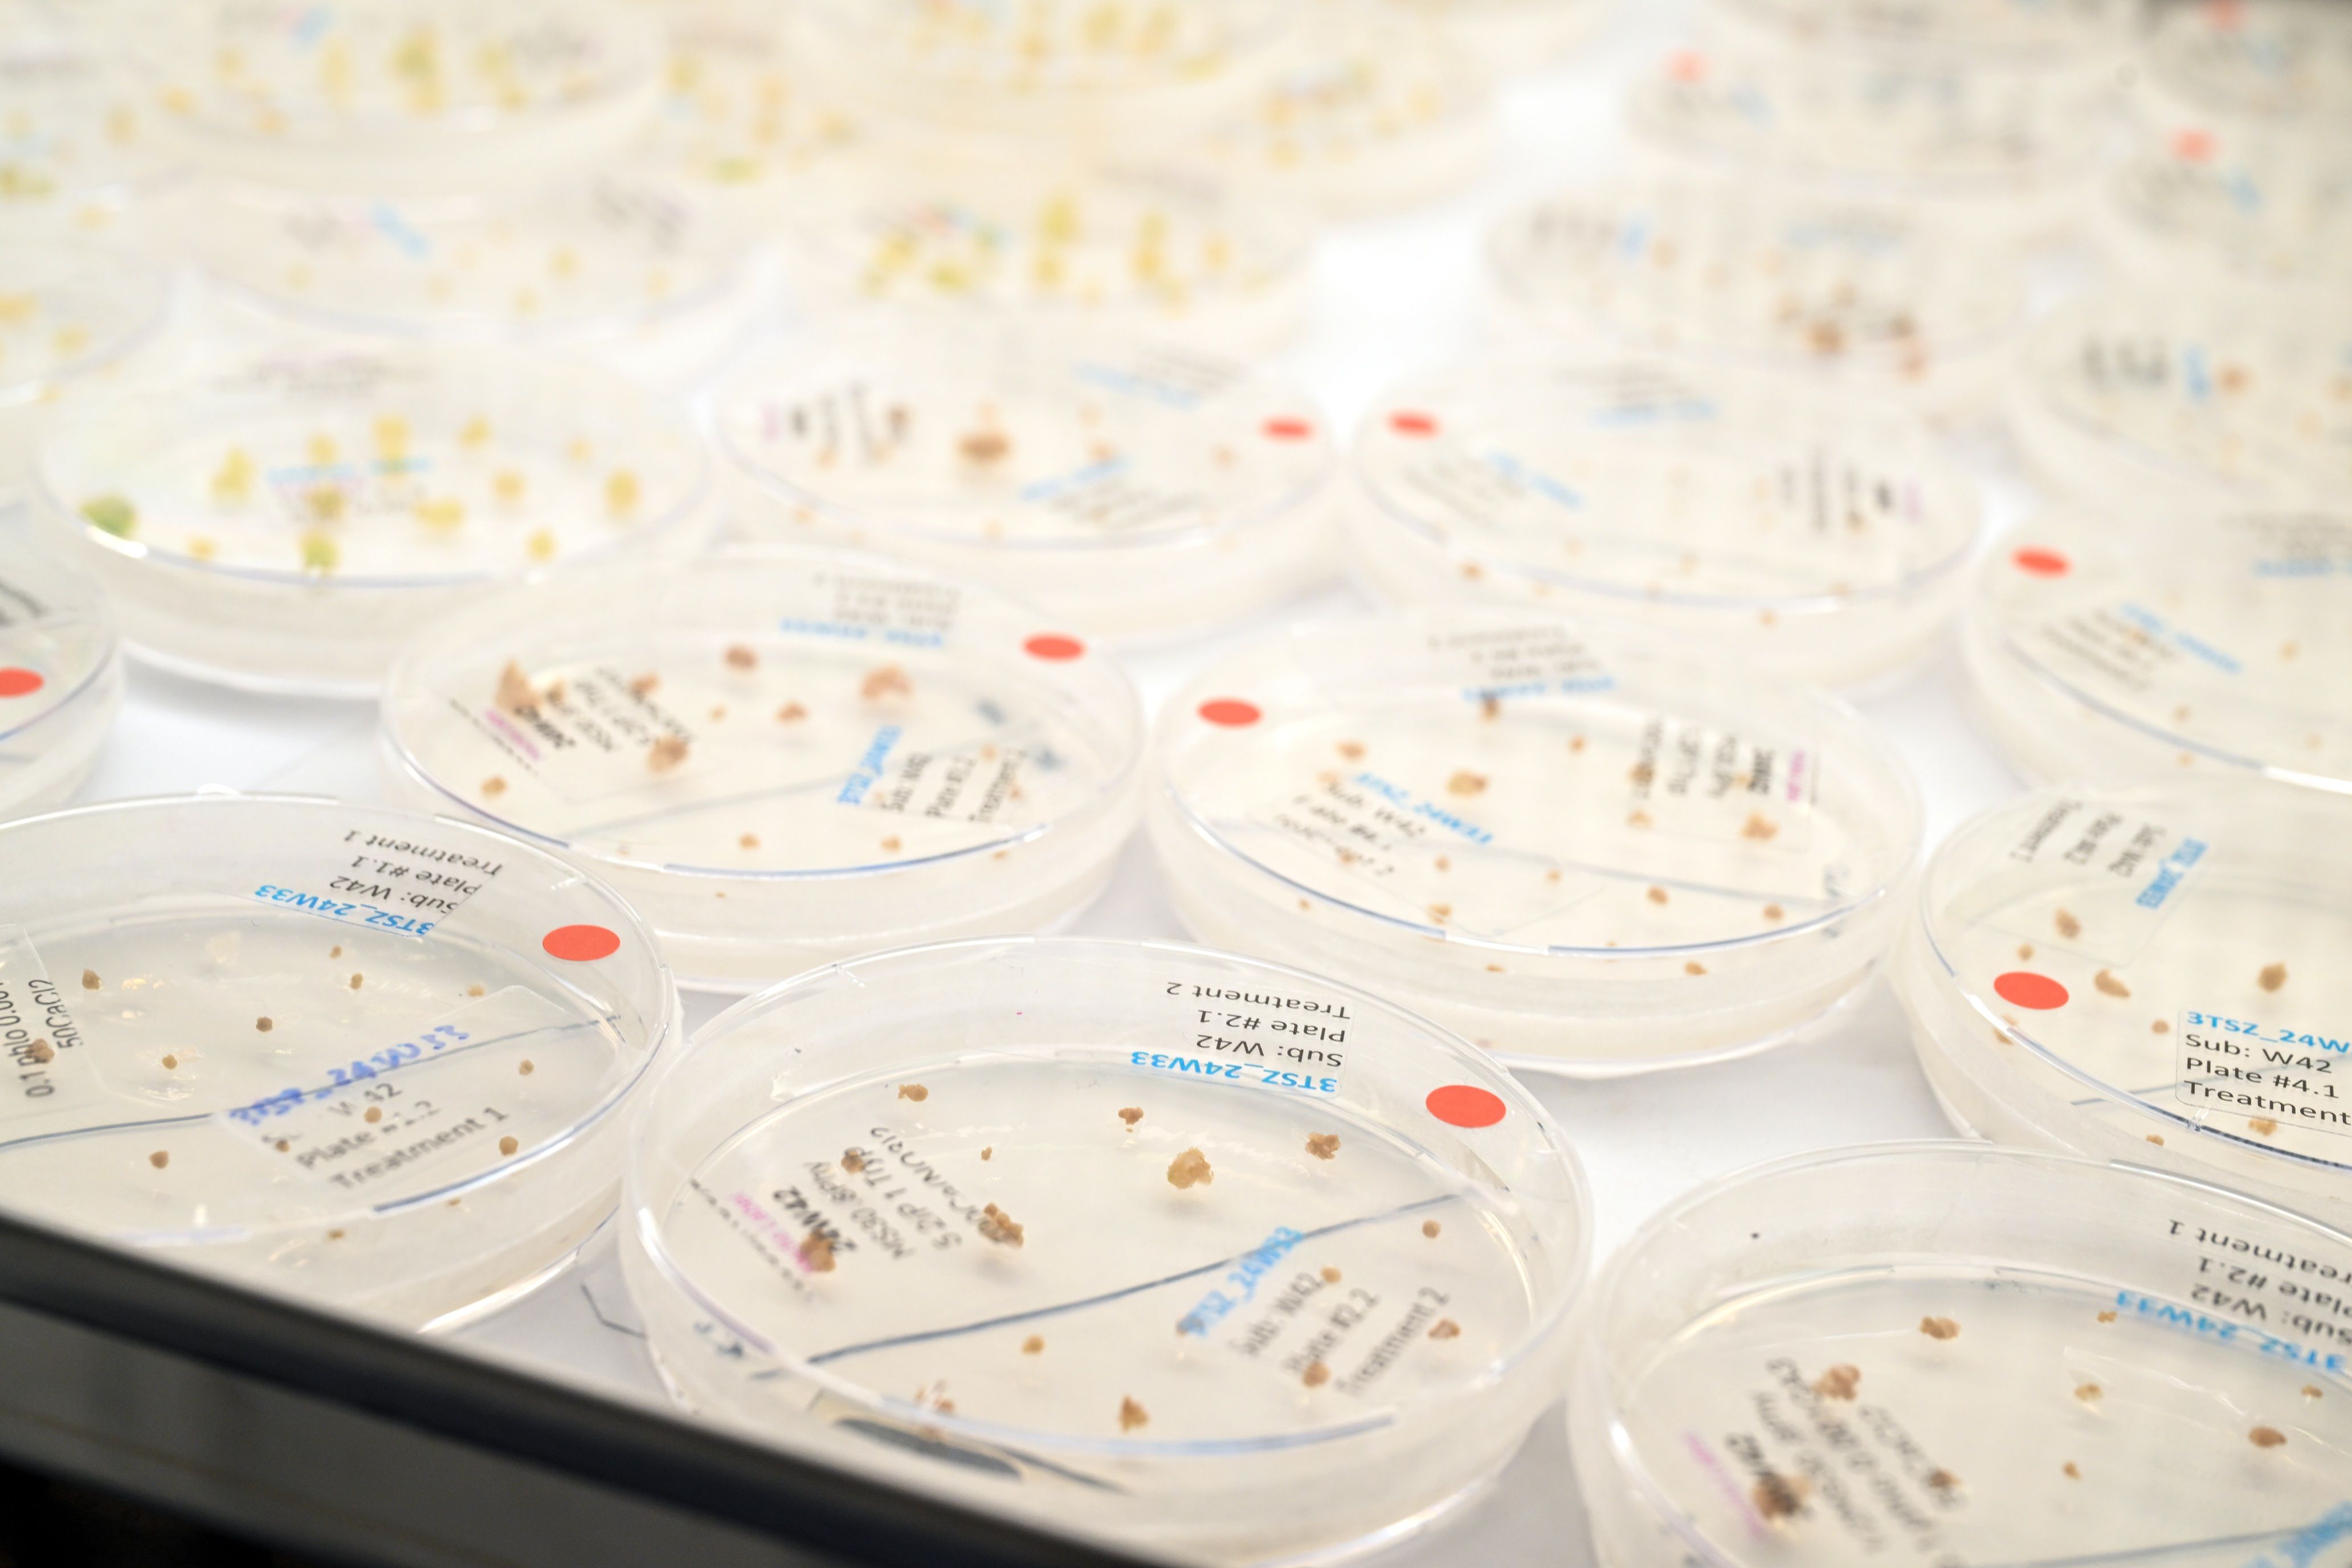
eb241028 wageningen hudson128k.jpg

Duurzame landbouw in stroomversnelling door nieuwe veredelingstechnieken
Het Wageningse biotechbedrijf Hudson River Biotechnology verbetert gewassen met geavanceerde CRISPR-technologie. Het bedrijf is in staat om op moleculair niveau eigenschappen van planten te verbeteren voor bijvoorbeeld ziekteresistentie. Het ontwikkelen van knowhow vraagt tijd. Dankzij de investering van Oost NL krijgt het innovatieve bedrijf die tijd.

Wat doet Hudson River Biotechnology?
Ferdinand Los, CEO van Hudson River Biotechnology: ‘Wij passen CRISPR-technologie toe om op moleculair niveau aanpassingen te doen in genetisch plantenmateriaal. Zo zorgen we bijvoorbeeld voor fruit dat langer vers blijft, groente met meer voedingswaarde of een grotere oogst. Normaal gesproken duurt een gewasaanpassing zeven tot tien jaar. Wij kunnen het met onze innovatieve technologie in twee tot vier jaar.’
‘Naast de genetica richten wij ons op ‘crop care’: het ontwikkelen van specifieke gewasbeschermingsmiddelen om een plant te laten groeien. Traditionele bestrijdingsmiddelen zijn vaak weinig specifiek en doden veel van wat leeft op en rondom de plant. Dat heeft vaak nadelige en milieuonvriendelijke gevolgen. Wij ontwikkelen biologische gewasbescherming die heel specifieke bescherming biedt, bijvoorbeeld tegen insecten of onkruid, zonder de nadelige gevolgen.’
Welk maatschappelijk probleem lost Hudson River Biotechnology op?
Wout Morrenhof, investment manager Oost NL: ‘De bevolking groeit en er moeten wereldwijd steeds meer monden worden gevoed. Hudson zorgt er via hun innovatieve technologie voor dat gewassen minder vatbaar worden voor ziektes, beter bestand zijn tegen extreme weersomstandigheden en resistent worden tegen bepaalde schimmels. Dit leidt tot minder verspilling en hogere opbrengsten wat door klimaatverandering steeds harder nodig is.’
Los: ‘Onze activiteiten dragen allebei bij aan het verminderen van de impact van landbouw op het milieu. Wij introduceren via CRISPR nieuwe planteneigenschappen die bijvoorbeeld de hoeveelheid water of chemische bestrijding die nodig is verminderen. Je pakt een probleem zoals een schimmel namelijk bij de bron al aan door een schimmelresistentie in te bouwen. Ook onze biologische bestrijdingsmiddelen dienen dat doel. Ik zou het persoonlijk een enorme mijlpaal vinden wanneer gebruik van het onkruidbestrijdingsmiddel glyfosaat in de akkerbouw in de komende tien jaar wereldwijd fors vermindert. Het is een efficiënt en goedkoop middel, maar het kan schadelijk zijn voor mensen, dieren en het bodemleven.’
Op welke manier draagt Oost NL bij aan jullie innovatie?
Los: ‘We hebben een ‘runway’ nodig totdat we onze eigen broek kunnen ophouden. Maar het is niet alleen de financiering die voor ons het verschil maakt. Feit is dat Oost NL een betrokken sparringpartner is, die strategisch met ons meedenkt. Oost NL helpt ons ook bij het uitbouwen van ons regionale netwerk, met contacten bij overheden en bij het vergaren van kennis van de sector. Adviseur Jouke Kardolus bijvoorbeeld, kent iedereen en legt gemakkelijk warme contacten voor ons.’
Morrenhof: ‘Wij investeren in Hudson vanuit het Innovatie- en Energiefonds Gelderland. Dit is een fonds waarmee we innovaties versterken, die nog in een risicovolle fase verkeren. Hudson bevindt zich in een fase van commerciële opschaling. Daarnaast wordt de technologie continu doorontwikkeld. Dit vergt tijd en financiering.’
Wat brengt de samenwerking jullie?
Morrenhof: ‘Het Spaanse agro-innovatie bedrijf Eurogenetic is enthousiast over Hudson en is bereid gebleken hierin te investeren. Hun geloof in deze technologie onderstreept de marktpotentie. De internationale belangstelling bewijst dat Hudson toonaangevend is en een radicale verandering in plantveredeling en tuin- en akkerbouw teweeg kan brengen. Daarom zijn we gezamenlijk als investeerders ingestapt. De nauwe samenwerking met Hudson heeft vanaf het eerste contact sterk bijgedragen aan de succesvolle financiering vanuit Oost NL.’
Los: ‘De betrokkenheid van Oost NL is een soort kwaliteitskeurmerk: daardoor raken ook andere investeerders enthousiast. In deze fase moeten wij een droom verkopen, die pas in de toekomst uit zal komen. Dat is een risicovolle fase. De steun van Oost NL is dan vergelijkbaar met een golf die onder je surfplank omhoogkomt: ineens word je vooruit gestuwd.’
